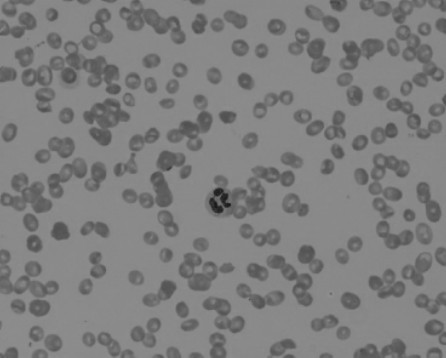

Text A Anemia
Approach to the Anemia

Fig.12-1 Microscopic examination of hypoferric/iron deficiency anemia

Fig.12-2 Microscopic examination of aplastic anemia
Anemia is defined as a significant reduction in the mass of circulating red blood cells.As a result,the oxygen binding capacity of the blood is diminished. Because blood volume is normally maintained at a nearly constant level,anemic patients have a decrease in the concentration of red cells or hemoglobin in peripheral blood(Fig.12-1,12-2).Hemoglobin and hematocrit levels vary with the age of the individual and,in adults,with gender.The values in women of childbearing age are 10%lower than those in men.Anemic patients'values are more than one standard deviation below the mean values for their gender. However,because of the wide range in normal hemoglobin and hematocrit levels,it is often difficult to document mild anemia.
Sometimes the diagnosis of anemia is confounded by a concomitant change in the plasma volume.For example,if a patient with a low red cell mass sustains a loss of plasma volume from dehydration,diarrhea,vomiting,or severe burns,the blood hemoglobin and hematocrit levels will be increased and may even be in the normal range.Another important example is acute hemorrhage,in which the loss of both red blood cells and plasma results in a false elevation of hemoglobin and hematocrit.In contrast,hemoglobin and hematocrit values may be falsely low in patients with an expanded plasma volume,such as in pregnancy or congestive heart failure.
Pathobiology
In any organ or region of the body,the transport of oxygen is a product of three independent variables expressed in the Fick equation.The middle variable—the oxygen carrying capacity of the blood—is,by definition,low in anemic patients.The two other variables in the Fick equation undergo compensatory changes that,as explained later,greatly enhance oxygen transport.
Blood Flow
Anemia has a marked impact on blood flow,the left-hand variable in the Fick equation.In all anemic individuals,there is enhanced flow to vital organs, including the heart,brain,liver and kidneys,at the expense of nonvital organs.Anemic patients are pale because blood is diverted away from the skin and mucous membranes to preserve oxygen supply to the critical organs. Resting cardiac output is normal in patients with mild or moderate anemia,but with exercise,it increases more than that of a normal individual.In severe anemia,resting cardiac output is increased,putting patients at risk of developing high-output cardiac failure,particularly those with coronary artery insufficiency or other types of preexisting cardiac disease.
Oxygen Binding to Hemoglobin
The variable on the right side of the Fick equation is the difference in fractional oxygenation between the arterial and venous blood.This difference in oxygen saturation is determined by the hemoglobin oxygen binding curve.At any given oxygen tension(Pa O2),the oxygen saturation of hemoglobin is lower. Thus,red cells of anemic patients have decreased oxygen affinity.This change is due entirely to elevated levels of red cell 2,3-diphosphoglycerate(2,3-DPG,2,3-二磷酸甘油酯)in red cells.This glycolytic intermediate is the principal determinant of oxygen affinity in human red cells.The Pa O2in arterial blood is normally approximately 95 mm Hg,resulting in nearly 100%oxygen saturation. During the transit of red cells from an artery through its capillary bed to its vein,oxygen is released to respiring cells.In normal individuals,at a normal venous Pa O2of about 40 mm Hg,the oxygen saturation is approximately 80%. In contrast,in patients with anemia and elevated red cell 2,3-DPG levels,the lower oxygen affinity of their red cells enables a much higher fraction of the oxygen(about 45%)to be unloaded.One gram of hemoglobin binds up to 1.34 m L of oxygen under standard conditions of temperature and pressure.Thus,in a normal individual having a hemoglobin of 15 g/d L,the oxygen carrying capacity of the blood is 15×1.34,or 20 m L O2/d L.As mentioned earlier,20%of this oxygen will be unloaded—that is,4 m LO2/10 d L blood during arterial-venous transit.In contrast,an anemic patient with a hemoglobin of 7.5 g/d L has an oxygen binding capacity that is half normal,or 10 m L O2/d L.If this patient had red cells with normal oxygen affinity,20%,or only 2 m L of oxygen,would be unloaded per 100 m L of blood.However,because the patient's red cells have a lower affinity for oxygen,3.5 m L is unloaded,nearly as much as normal. Thus,the decrease in oxygen affinity is an important mechanism by which anemic patients compensate for the deficit in red cell mass.
Methemoglobinemia
In order for hemoglobin to reversibly bind oxygen,the iron atom in the heme must be in the reduced(Fe2+)valence state.As red cells circulate,the heme iron slowly auto-oxidizes to Fe3+,forming methemoglobin,which is incapable of binding oxygen.Normal red cells are endowed with a very efficient enzymatic pathway composed of cytochrome b5,cytochrome b5reductase,and NADH(还原型辅酶)that rapidly reduces the iron in methemoglobin back to its fucntional Fe2+form.Thus,normal red cells contain less than 0.5%methemoglobin.However,either an inherited deficiency in cyochrome b5reductase or exposure to an oxidant drug or toxin can result in methemoglobinemia. Laboratory samples of blood containing methemoglobin are dark brown, whereas patients with greater than 10%methemoglobinemia have cyanosis,a blue discoloration of the skin indistinguishable from that commonly seen in patients having normal hemoglobin but low oxygen saturation owing to pulmonary or cardiac disease.In many hospitals and large clinical laboratories, the instrument that measures oxygen saturation in blood samples also provides an accurate determination of methemoglobin.
Patients with congenital methemoglobinemia inherit an autosomal recessive deficiency in cytochrome b5reductase.Heterozygote relatives have low or undetectable methemoglobin levels,whereas affected individuals(homozygotes and compound heterozygotes)generally have 10%to 35% methemoglobin. These individuals are generally asymptomatic owing to the fact that the methemoglobin is distributed primarily in the older population of red cells. Nevertheless,many affected individuals have cosmetic concerns.Treatment with oral ascorbic acid or riboflavin is effective in lowering the level of methemoglobin below the threshold of detectable cyanosis.
A variety of drugs can cause methemoglobinemia,including acetaminophen (Tylenol,泰诺),dapsone,nitroprusside,amyl nitrate,and procaine congeners used for local anesthesia.It is not clear why only a very small fraction of those using these drugs develop this complication,but some affected individuals have been shown to be heterozygous for cytochrome b5reductase deficiency.When these drugs are taken in prescribed doses,methemoglobinemia seldom reaches levels high enough to cause clinical concern.
In contrast,individuals exposed to industrial toxins such as nitrite,nitrate or aniline may develop life-threatening levels of methemoglobin.The threshold at which symptoms occur is highly variable.Acute induction of 20%methemoglobin may cause fatigue;at 30%,individuals often develop tachycardia.When methemoglobin exceeds 50%,patients experience weakness,breathlessness, and confusion.At 70%to 80%,coma and death may occur.The toxicity of methemoglobinemia is not just because of the oxidized hemes'inability to bind oxygen;the remaining functional(Fe2+)hemes in the hemoglobin tetramer have increased oxygen affinity and therefore are much less effective in releasing oxygen to tissues.Patients with toxic methemoglobinemia can be effectively treated with intravenous infusion of methylene blue(1 to 2 mg/kg).
Regulation of Erythropoiesis by Erythropoietin
Anemia also impacts the middle component of the Fick equation.As mentioned earlier,hemoglobin levels are,by definition,low in anemic patients.The resultant decrease in the oxygen carrying capacity of the blood causes cellular hypoxia.In all cells of the body,a molecular sensor detects even modest degrees of low oxygen tension and induces a hypoxia inducible transcription factor called HIF(hypoxia-inducible factor,低氧诱导因子).HIF upregulates expression of the hormone erythropoietin in the kidney and,to a less extent,in the liver.Erythropoietin binds to a specific receptor abundantly expressed on erythroid progenitor cells in the bone marrow and salvages these cells from apoptosis,thereby enhancing red blood cell production.Normal individuals maintain nearly constant levels of circulating red cells by finely tuned regulation of erythropoietin production.In anemic patients,the hypoxic signal in the kidneys and,to a lesser extant,in the liver results in a robust induction of erythropoietin expression.As the hematocrit falls,the plasma erythropoietin level rises markedly;in severely anemic patients,it may be 1,000-fold higher than normal.In patients with anemia due to impaired red cell production,their erythroid progenitors are unresponsive to such high levels of plasma erythropoietin.In contrast,in patients whose anemia is due to hemolysis or blood loss,elevated erythropoietin levels maximize red cell production.
Clinical Manifestations
The history and physical examination may reveal additional findings peculiar to specific causes of anemia or to other comorbid conditions.The degree to which symptoms occur in an anemic patient depends on several contributing factors.If the anemia has developed rapidly,there may not have been adequate time for compensatory adjustments to take place,and the patient may have more marked symptoms than if an anemia of equivalent severity had developed insidiously.Furthermore,the patient's complaints may depend on the presence of local vascular disease.For example,symptoms owing to ischemia in patients with angina pectoris,intermittent claudication,or transient cerebral episodes may be triggered by the development of anemia.
Symptoms
Many individuals with mild anemia have no complaints and are unaware that they have“tired blood”.Others may complain of fatigue as well as dyspnea and palpitations,particularly following exercise.Patients with severe anemia are often symptomatic at rest and are unable to tolerate significant exertion.If the hemoglobin concentration falls below7.5 g/d L,resting cardiac output is likely to rise,with an increase in both stroke volume and heart rate.The patient may be aware of this hyperdynamic state and complain of a rapid, pounding sensation in the precordium.Patients with compromised myocardial reserve may develop complaints due to cardiac failure.
The symptoms of severe anemia often extend beyond the cardiac or circulatory system.Patients sometimes experience dizziness and headache and, less often,syncope,tinnitus,or vertigo.Many are irritable and have difficulty sleeping or concentrating.Because blood flow is shunted away from the skin, patients may complain of increased sensitivity to cold.In like manner, gastrointestinal symptoms such as indigestion,anorexia,or even nausea are attributable to the shunting of blood away from the splanchnic bed.Females commonly develop abnormal menstruation,either amenorrhea or increased bleeding.Males may experience impotence or loss of libido.
Physical Findings
Pallor is the most commonly encountered physical finding in patients with anemia.As mentioned earlier,this sign is due to the shunting of blood away from the skin and other peripheral tissues,permitting enhanced blood flow to vital organs.The usefulness of pallor as a physical finding is limited by other factors that affect the appearance of the skin.Blood flow to the skin may undergo wide fluctuations.Moreover,the skin's thickness and texture vary widely among individuals.Those with a fair complexion may appear pale even though they are not anemic,while pallor is difficult to detect in deeply pigmented individuals.The amount of melanin in the epidermis is an important determinant of skin color.Pallor may be difficult to detect in patients who have increased melanin pigmentation due to Addison disease(阿狄森病/原发性肾上腺皮质功能减退症)or hemochromatosis.Nevertheless,even in blacks,the presence of anemia may be suspected by the color of the palms or of noncutaneous tissues such as oral mucous membranes,nail beds,and palpebral conjuctivas.When the creases of the palm are as pale as the surrounding skin, the patient usually has a hemoglobin of less than 7 g/d L.
In addition to tachycardia,wide plus pressure,and hyperdynamic precordium,a systolic ejection murmur is often heard over precordium, particularly at the pulmonic area.In addition,a venous hum may be detected over the neck vessels.These findings disappear when the anemia is corrected.
(1,900 words)
New Words and Phrases
deviation[diːvɪ'eɪʃən]n. 背离,偏差
equation[ɪ'kweɪʃən]n. 方程式,等式;平衡
affinity[ə'fɪnətɪ]n. 亲和性,吸引力
diphosphoglycerate[daɪ,fɒsfəʊ'ɡlɪsəreɪt]n. 二磷酸甘油酯
glycolytic[ɡlaɪkə'lɪtɪk]a. 糖酵解的
methemoglobinemia[,methiːməʊ,ɡləʊbɪ'niːmɪə]n.高铁血红蛋白血症
heme[hiːm]n. 血红素
valence['veɪləns]n. 原子价
endow[ɪn'daʊ]v. 赋予;具有
reductase[rɪ'dʌkteɪs]n. 还原酶
autosomal[ɔːtəʊ'səʊməl]a. 常染色体的
recessive[rɪ'sesɪv]a. 隐性的,退行的n. 隐性性状
cyanosis[saɪə'nəʊsɪs]n. 发绀,青紫
heterozygote[hetərəʊ'zaɪɡəʊt]n. 异形接合体
riboflavin[raɪbəʊ'fleɪvɪn]n. 核黄素,维生素B2
dapsone['dæpsəʊn]n. 氨苯砜
nitroprusside[,naɪtrəʊ'prʌsaɪd]n. 硝普钠
nitrate['naɪtreɪt]n. 硝酸盐
procaine['prəʊkeɪn]n. 普鲁卡因
congener['kɒndʒɪnə]n. 同类的人(或东西)
nitrite['naɪtraɪt]n. 亚硝酸盐
aniline['ænɪliːn]n. 苯胺
coma['kəʊmə]n. 昏迷
tetramer['tetrəmə]n. 四聚物
methylene['meθɪliːn]n. 亚甲基
erythropoiesis[ɪ,rɪθrəʊpɒɪ'iːsɪs]n. 红细胞生成
hypoxia[haɪ'pɒksɪə]n. 低氧;氧不足
transcription[træn'skrɪpʃən]n. 转换;转录
erythroid['erɪθrɒɪd]a. 红色的;红细胞的
progenitor[prəʊ'dʒenɪtə]n. 祖先,祖代
salvage['sælvɪdʒ]n. 抢救
apoptosis[,æpəp'tɒsɪs]n. 细胞凋亡
hemolysis[hɪ'mɒlɪsɪs]n. 溶血
insidiously[ɪn'sɪdɪəslɪ]ad. 隐袭地;阴险地
pectoris['pektərɪs] 绞痛
palpitation[,pælpɪ'teɪʃən]n. 心悸
precordium[priː'kɔːdɪəm]n. 心前区
syncope['sɪŋkəpɪ]n. 晕厥
tinnitus[tɪ'naɪtəs]n. 耳鸣
vertigo['vзːtɪɡəʊ]n. 眩晕
impotence['ɪmpətəns]n. 阳痿;无能力
fluctuation[flʌktʃuː'eɪʃən]n. 波动,起伏
melanin['melənɪn]n. 黑色素
epidermis[,epɪ'dзːmɪs]n. 表皮纤维,表皮素
crease[kriːs]n. 皱折,折痕v.(使)起皱
murmur['mзːmə]n. 杂音
hum[hʌm]n. 连续低沉的声音(如嗡嗡声、营营声等)
 Exercises
Exercises
Ⅰ.Reading Comprehension
A.Answer the following questions.
1.What does anemia impact on?
2.Why will the blood hemoglobin and hematocrit levels be increased and may even be in the normal range?
3.What drugs can cause methemoglobinemia?
4.What do the symptoms of both mild and severe anemia include?
5.What are the consequences of exposing to the industrial toxins?
B.Decide whether the following statements are True or False.
1.Because blood volume is normally maintained at a nearly constant level, anemic patients have an increase in the concentration of red cells or hemoglobin in peripheral blood.
2.However,because of the wide range in abnormal hemoglobin and hematocrit levels,it is often difficult to document mild anemia.
3.Hemoglobin and hematocrit values may be falsely low in patients with an expanded plasma volume,such as in pregnancy or congestive heart failure.
4.In all anemic individuals,there is enhanced flow to vital organs,including the heart,brain,liver and kidneys,at the expense of nonvital organs.
5.The variable on the right side of the Fick equation is the same in fractional oxygenation between the arterial and venous blood.
Ⅱ.Words and Expressions
A.Fill in the blanks with the words and expressions given below,and change the form where necessary.
respective anemia hyperoxia concomitant compensatory
competence recessive tachycardia recessus erythropoietin
erythropoiesis syncope fluctuation compromise hypoxia
1.Proliferation of fibroblastic cells in bone marrow causes__________ and sometimes enlargement of the spleen and liver.
2.When patients have a__________ disease or injury indicating antibiotics,they should be used.
3.Should the__________ adjustment remain unacceptable,negotiations should be continued.
4.The reports said blond hair was caused by a__________ gene,so both sides of the family have to have it to extend the shade into the next generation.
5.__________:Heart rate over 100(as high as 240)beats per minute.
6.Results:Show the dose,methods and side effects of recombinant human__________ to premature infants with anemia.
7.Stroke[or cerebrovascular accident(CVA),脑血管意外]:Sudden impairment of brain function due to__________ ,which may cause death of brain tissue.
8.Dr.William Ravich said choking can cause a person to faint,an occurrence known as vasovagal__________ .
9.The present price__________ in the world market have necessitated the adjustment of price for bitter apricot kernel(苦杏仁).
10.Interactions that are classified as adverse either__________ therapeutic efficacy,enhance toxicity,or both.
B.Fill in the blanks with the suitable words or expressions from each group.
Because anemia is so obviously abnormal,it has always 1 medical curiosity.For many years the distinction between the lay term“pallor”and the medical term“ 2 ”meant very little so far as exact knowledge was concerned.Although 3 were made between so-called primary and secondary types,very little progress was made in understanding the 4 processes concerned in the development of anemia until about twenty years ago. The accelerated interest in the 5 of anemia following the remarkable success of liver therapy in pernicious anemia has led to many 6 discoveries, among which may be listed the conception that the gastrointestinal tract and pernicious anemia are closely 7 ,the development of knowledge regarding the iron-deficiency state,and the important realization that anemia is frequently a manifestation of a 8 deficiency state.
Anemia may be defined as that portion of an abnormal bodily state which is characterized by a reduction either in the 9 or in the red blood-cell content.Undue attention has often been paid to anemia as such,to the exclusion of the underlying 10 which have brought it about.Except possibly after hemorrhage,anemia is never an isolated 11 but is always an integral part of a more widespread disturbance.It is probably best,therefore,to consider anemia as a 12 ,comparable in nature to dyspnea and 13 . According to this conception all anemia may thus be considered secondary to some cause,whether or not this cause is readily discernible.If this premise is correct,there can be no 14 anemia,and the designation“secondary”is meaningless,so that other terms must be used.Before discussing these, however,we shall review the 15 by which anemia develops;this in turn entails a discussion of normal blood formation.
The nucleated red blood cells,which are formed in the widely scattered bone 16 and which eventually enter the blood stream without nuclei,are the products of the integrated functioning of many body 17 .The red blood cell is composed in great part of hemoglobin,an active 18 capable of a very large number of chemical exchanges with oxygen and carbon dioxide.The hemoglobin molecule is an extremely large one composed of 19 ,globin and iron-porphyrin(铁卟啉)—apigment closely allied to chlorophyll.Thus in the formation of hemoglobin both protein and iron are essential substances,with the possibility that preformed pyrrole(吡咯)groupings derived from plants are also necessary.These substances are obtained only from food,which thus becomes the first of the important factors in normal 20 .
1.A.raised B.aroused C.risen D.arisen
2.A.hemology B.bleed C.anemia D.hemorrhage
3.A.distinctions B.destinations C.distinguish D.destruction
4.A.physical B.physiological C.physiopathologic D.physic
5.A.development B.observation C.understanding D.study
6.A.basis B.foundational C.functional D.fundamental
7.A.interrelated B.relevant C.interferent D.interaction
8.A.half B.portion C.generalized D.general
9.A.hemolysis B.hemoglobin C.hemodynamic D.leukocyte
10.A.abnormalities B.conditions C.instants D.cases
11.A.phenomenon B.characteristic C.indication D.manifestation
12.A.sign B.syndrome C.symptom D.expression
13.A.cycle B.cynic C.cylinder D.cyanosis
14.A.primary B.pernicious C.iron-deficiency D.aplastic
15.A.progress B.processes C.actions D.ways
16.A.morrow B.marrow C.medulla D.medium
17.A.organs B.systems C.cells D.tissues
18.A.component B.chemistry C.compound D.composition
19.A.amino acid B.iron C.vitamin D.protein
20.A.hematocrit B.hemochromatosis(血色素沉着症,血色病) C.hemodynamic D.hematopoiesis
Ⅲ.Translation
A.Translate the following short passages into Chinese.
1.The symptoms of severe anemia often extend beyond the cardiac or circulatory system.Patients sometimes experience dizziness and headache and,less often,syncope,tinnitus,or vertigo.Many are irritable and have difficulty sleeping or concentrating.Because blood flow is shunted away from the skin,patients may complain of increased sensitivity to cold.In like manner,gastrointestinal symptoms such as indigestion,anorexia,or even nausea are attributable to the shunting of blood away from the splanchnic bed.
2.The history and physical examination may reveal additional findings peculiar to specific causes of anemia or to other comorbid conditions.The degree to which symptoms occur in an anemic patient depends on several contributing factors.If the anemia has developed rapidly,there may not have been adequate time for compensatory adjustments to take place,and the patient may have more marked symptoms than if an anemia of equivalent severity had developed insidiously.
3.When methemoglobin exceeds 50%,patients experience weakness, breathlessness,and confusion.At 70%to 80%,coma and death may occur.The toxicity of methemoglobinemia is not just because of the oxidized hemes'inability to bind oxygen;the remaining functional(F2+) hemes in the hemoglobin tetramer have increased oxygen affinity and therefore are much less effective in releasing oxygen to tissues.Patients with toxic methemoglobinemia can be effectively treated with intravenous infusion of methylene blue(1 to 2 mg/kg).
B.Translate the following short passages into English.
1.对于已确诊和及时治疗的患者,维持其正常寿命是可能的。如果未经治疗,血色素沉着症可导致器官严重损伤,甚至死亡。
2.除了报告红细胞数和血红蛋白水平外,自动计数器也可通过血细胞计数(flow cytometry)测出红细胞大小,这是区别贫血病因的重要工具。显微镜下血液涂片检查也可作为辅助手段。
Ⅳ.Writing
A.Write an abstract of Text A.
B.Write a topic-related and literature-based report on Anemia.

Exercises
Exercises